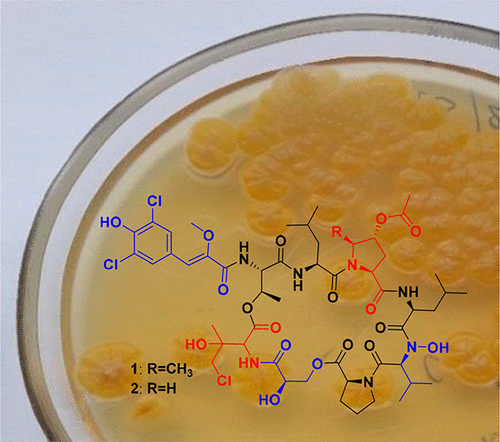

Our students Anastasia Andrianova, Anastasia Khokhlova, Anastasia Fadeeva & Aleksandr Makhin visited the Scientific School-Conference "Current Topics in Organic Chemistry", which took place in Sheregesh, Kemerovo Region during March 15th - 21st, 2024. Issues pertaining to structure and reactivity of organic compounds, molecular design and synthesis, biochemistry, polymers and organic materials were discussed. We were pleased to introduce our flash presentations on recent advances in Henlea earthworm bioluminescence, fungal bioluminescence and SARS-CoV-2 inhibitors development. Congratulations to Anastasia Khokhlova for the best flash presentation!
21st International Symposium on Bioluminescence and Chemiluminescence
Alexey Kotlobay, Aleksandra Tsarkova, Zinaida Osipova, Karen Sarkisyan & Ilia Yampolsky visited 21st International Symposium on Bioluminescence and Chemiluminescence hosted along with XIX International Symposium on Luminescence Spectrometry by University of Oviedo, which took place in Gijon, Spain during May 31st- June 3rd, 2022. Many presentations about recent advances in chemiluminescence and bioluminescence, fruitful interactions and discussions - we were happy to meet our friends and colleagues from around the world!